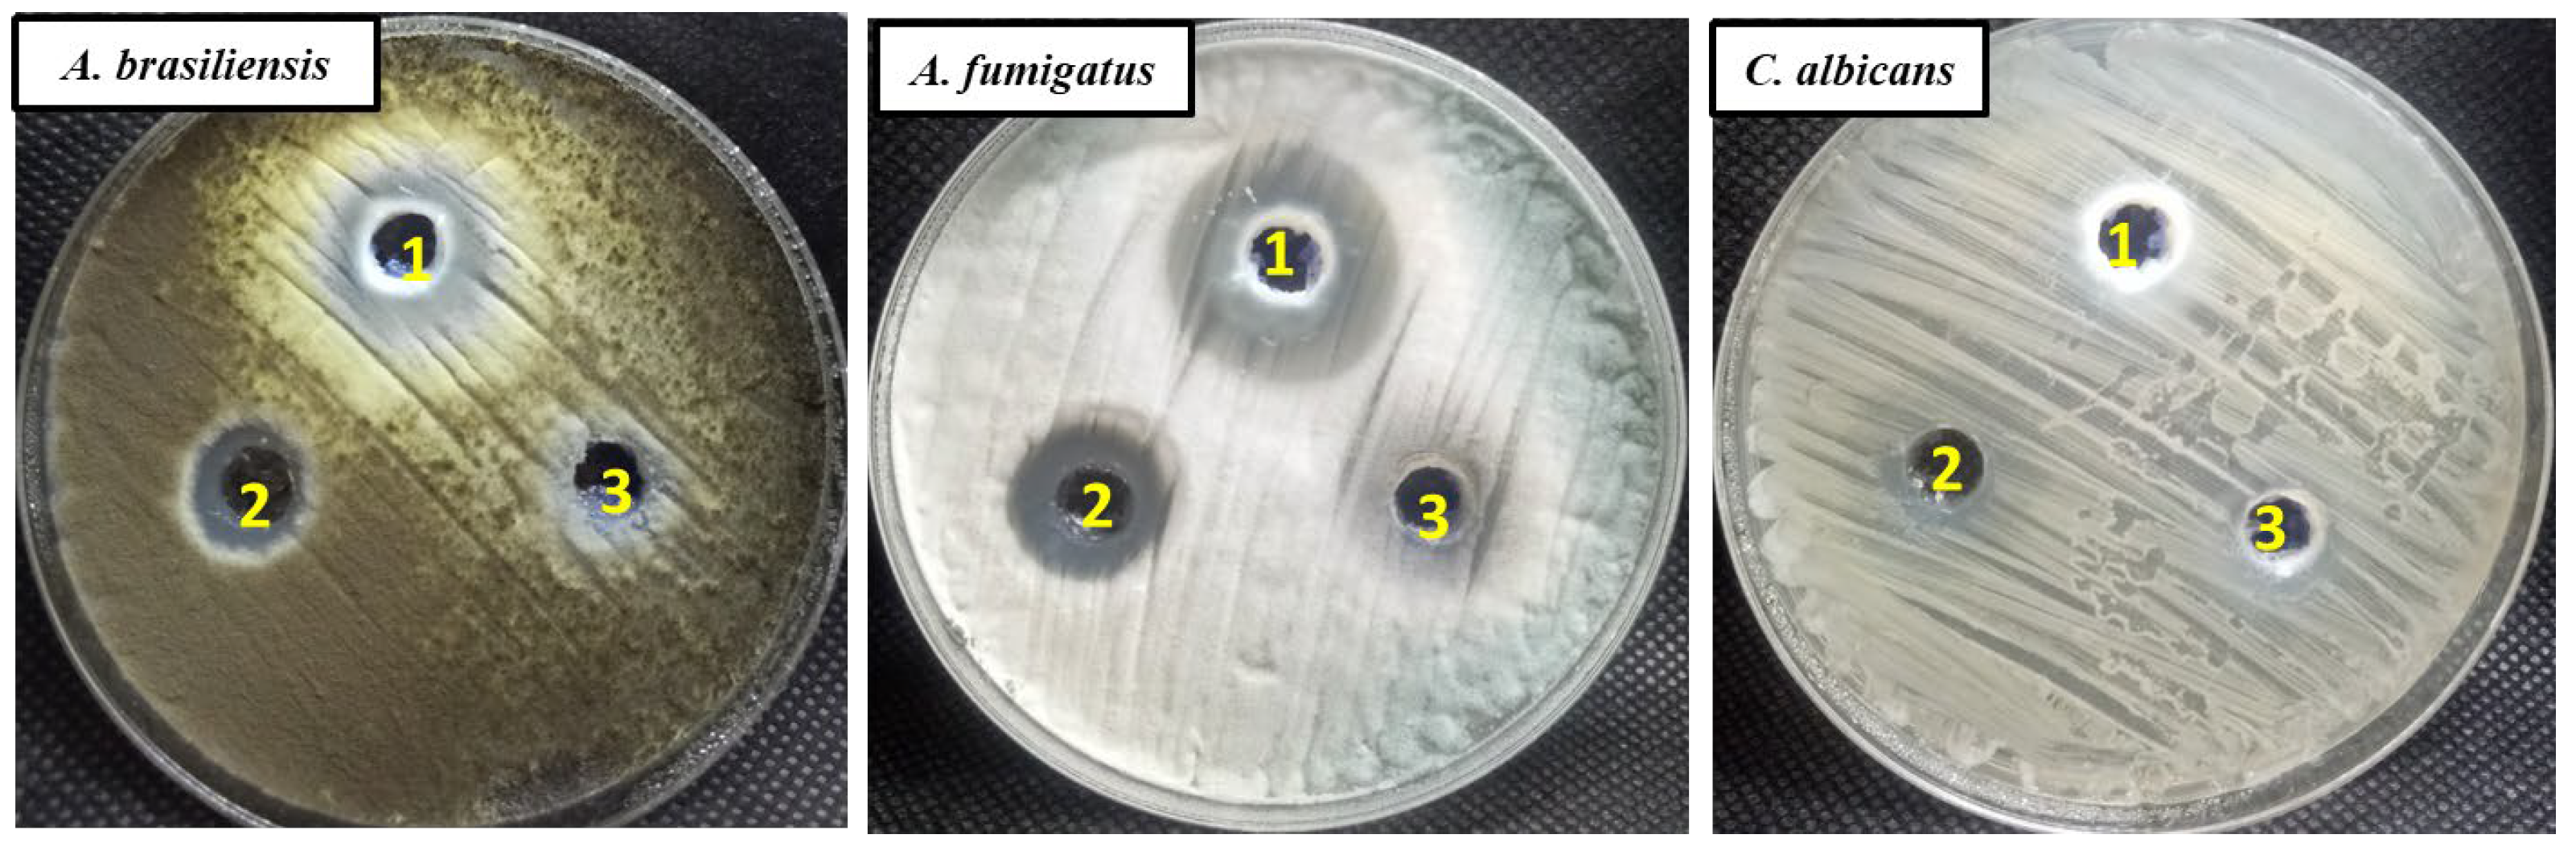

Thymus Vulgaris Oil Nanoemulsion: Synthesis, Characterization, Antimicrobial and Anticancer Activities
Abstract
:1. Introduction
2. Results and Discussion
2.1. Preparation and Characterization of Th-nanoemulsion
2.2. In Vitro Antimicrobial Activity
2.3. Antifungal Activity
2.4. Cytotoxic Effect of Th-emulsion and Th-nanoemulsion on MCF-7 and HepG2 Cancer Cell Lines
2.5. Effect of Th-emulsion and Th-nanoemulsion on Caspase-8 and Caspase-9 Activities
2.6. Effect of Th-emulsion and Th-nanoemulsion on VEGFR-2
3. Materials and Methods
3.1. Chemicals and Reagents
3.2. Preparation of Nanoemulsion (NE)
3.3. Measurement of Particle Size
3.4. Transmission Electron Microscopy (TEM)
3.5. Antibacterial Activity
3.6. Antifungal Activity
3.7. Anti-Proliferative Activity
3.8. Evaluation of Caspase-8 and Caspase-9 Activities
3.9. Assessment of the VEGFR-2 Concentration
3.10. Statistical Analysis
4. Conclusions
Author Contributions
Funding
Institutional Review Board Statement
Informed Consent Statement
Data Availability Statement
Acknowledgments
Conflicts of Interest
Sample Availability
References
- Beyene, B.; Beyene, B.; Deribe, H. Review on application and management of medicinal plants for the livelihood of the local community. J. Resour. Dev. Manag. 2016, 22, 33–39. [Google Scholar]
- Parham, S.; Kharazi, A.Z.; Bakhsheshi-Rad, H.R.; Nur, H.; Ismail, A.F.; Sharif, S.; RamaKrishna, S.; Berto, F. Antioxidant, antimicrobial and antiviral properties of herbal materials. Antioxidants 2020, 9, 1309. [Google Scholar] [CrossRef] [PubMed]
- English, B.K.; Gaur, A.H. The use and abuse of antibiotics and the development of antibiotic resistance. In Hot Topics in Infection and Immunity in Children VI; Springer: Berlin/Heidelberg, Germany, 2010; pp. 73–82. [Google Scholar]
- Meade, E.; Slattery, M.A.; Garvey, M. Bacteriocins, potent antimicrobial peptides and the fight against multi drug resistant species: Resistance is futile? Antibiotics 2020, 9, 32. [Google Scholar] [CrossRef] [PubMed]
- Gandhi, N.R.; Nunn, P.; Dheda, K.; Schaaf, H.S.; Zignol, M.; Van Soolingen, D.; Jensen, P.; Bayona, J. Multidrug-resistant and extensively drug-resistant tuberculosis: A threat to global control of tuberculosis. Lancet 2010, 375, 1830–1843. [Google Scholar] [CrossRef]
- Catalano, A.; Iacopetta, D.; Ceramella, J.; Scumaci, D.; Giuzio, F.; Saturnino, C.; Aquaro, S.; Rosano, C.; Sinicropi, M.S. Multidrug Resistance (MDR): A Widespread Phenomenon in Pharmacological Therapies. Molecules 2022, 27, 616. [Google Scholar] [CrossRef] [PubMed]
- Shehabeldine, A.M.; Al-Askar, A.A.; AbdElgawad, H.; Hagras, F.; Ramadan, A.; Kamel, M.R.; Ahmed, M.; Atia, K.; Hashem, A.H. Wound Dressing Scaffold with High Anti-biofilm Performance Based on Ciprofloxacin-Loaded Chitosan-Hydrolyzed Starch Nanocomposite: In Vitro and In Vivo Study. Appl. Biochem. Biotechnol. 2023. online ahead of print. [Google Scholar] [CrossRef] [PubMed]
- Terreni, M.; Taccani, M.; Pregnolato, M. New Antibiotics for Multidrug-Resistant Bacterial Strains: Latest Research Developments and Future Perspectives. Molecules 2021, 26, 2671. [Google Scholar] [CrossRef]
- Yılmaz, Ç.; Özcengiz, G. Antibiotics: Pharmacokinetics, toxicity, resistance and multidrug efflux pumps. Biochem. Pharmacol. 2017, 133, 43–62. [Google Scholar] [CrossRef]
- Mathur, G.; Nain, S.; Sharma, P.K. Cancer: An overview. Acad. J. Cancer Res. 2015, 8, 1–9. [Google Scholar]
- Sung, H.; Ferlay, J.; Siegel, R.L.; Laversanne, M.; Soerjomataram, I.; Jemal, A.; Bray, F.J. Global cancer statistics 2020: GLOBOCAN estimates of incidence and mortality worldwide for 36 cancers in 185 countries. CA Cancer J. Clin. 2021, 71, 209–249. [Google Scholar] [CrossRef]
- Debela, D.T.; Muzazu, S.G.; Heraro, K.D.; Ndalama, M.T.; Mesele, B.W.; Haile, D.C.; Kitui, S.K.; Manyazewal, T. New approaches and procedures for cancer treatment: Current perspectives. SAGE Open Med. 2021, 9, 20503121211034366. [Google Scholar] [CrossRef] [PubMed]
- Gholami-Ahangaran, M.; Ahmadi-Dastgerdi, A.; Azizi, S.; Basiratpour, A.; Zokaei, M.; Derakhshan, M. Thymol and carvacrol supplementation in poultry health and performance. Vet. Med. Sci. 2022, 8, 267–288. [Google Scholar] [CrossRef] [PubMed]
- Juven, B.; Kanner, J.; Schved, F.; Weisslowicz, H. Factors that interact with the antibacterial action of thyme essential oil and its active constituents. J. Appl. Bacteriol. 1994, 76, 626–631. [Google Scholar] [CrossRef] [PubMed]
- Najafloo, R.; Behyari, M.; Imani, R.; Nour, S. A mini-review of Thymol incorporated materials: Applications in antibacterial wound dressing. J. Drug Deliv. Sci. Technol. 2020, 60, 101904. [Google Scholar] [CrossRef]
- Hajibonabi, A.; Yekani, M.; Sharifi, S.; Nahad, J.S.; Dizaj, S.M.; Memar, M.Y. Antimicrobial Activity of Nanoformulations of Carvacrol and Thymol: New Trend and Applications. OpenNano 2023, 13, 100170. [Google Scholar] [CrossRef]
- Murugaiyan, J.; Kumar, P.A.; Rao, G.S.; Iskandar, K.; Hawser, S.; Hays, J.P.; Mohsen, Y.; Adukkadukkam, S.; Awuah, W.A.; Jose, R.A.M. Progress in alternative strategies to combat antimicrobial resistance: Focus on antibiotics. Antibiotics 2022, 11, 200. [Google Scholar] [CrossRef]
- Pinto, L.; Tapia-Rodríguez, M.R.; Baruzzi, F.; Ayala-Zavala, J.F. Plant Antimicrobials for Food Quality and Safety: Recent Views and Future Challenges. Foods 2023, 12, 2315. [Google Scholar] [CrossRef]
- Solans, C.; Izquierdo, P.; Nolla, J.; Azemar, N.; Garcia-Celma, M.J. Nano-emulsions. Curr. Opin. Colloid Interface Sci. 2005, 10, 102–110. [Google Scholar] [CrossRef]
- Wang, L.; Li, X.; Zhang, G.; Dong, J.; Eastoe, J. Oil-in-water nanoemulsions for pesticide formulations. J. Colloid Interface Sci. 2007, 314, 230–235. [Google Scholar] [CrossRef]
- Choi, H.; Mody, C.C. The long history of molecular electronics: Microelectronics origins of nanotechnology. Soc. Stud. Sci. 2009, 39, 11–50. [Google Scholar] [CrossRef]
- Lemmon, M.A.; Schlessinger, J. Cell signaling by receptor tyrosine kinases. Cell 2010, 141, 1117–1134. [Google Scholar] [CrossRef]
- Duffy, A.M.; Bouchier-Hayes, D.J.; Harmey, J.H. Vascular endothelial growth factor (VEGF) and its role in non-endothelial cells: Autocrine signalling by VEGF. In Madame Curie Bioscience Database; Landes Bioscience: Austin, TX, USA, 2013. [Google Scholar]
- Elkady, H.; Elwan, A.; El-Mahdy, H.A.; Doghish, A.S.; Ismail, A.; Taghour, M.S.; Elkaeed, E.B.; Eissa, I.H.; Dahab, M.A.; Mahdy, H.A.; et al. New benzoxazole derivatives as potential VEGFR-2 inhibitors and apoptosis inducers: Design, synthesis, anti-proliferative evaluation, flowcytometric analysis, and in silico studies. J. Enzym. Inhib. Med. Chem. 2022, 37, 403–416. [Google Scholar] [CrossRef] [PubMed]
- El-Metwally, S.A.; Elkady, H.; Hagras, M.; Husein, D.Z.; Ibrahim, I.M.; Taghour, M.S.; El-Mahdy, H.A.; Ismail, A.; Alsfouk, B.A.; Elkaeed, E.B.; et al. Design, synthesis, anti-proliferative evaluation, docking, and MD simulation studies of new thieno[2,3-d]pyrimidines targeting VEGFR-2. RSC Adv. 2023, 13, 23365–23385. [Google Scholar] [CrossRef] [PubMed]
- Yang, Z.; He, Q.; Ismail, B.B.; Hu, Y.; Guo, M. Ultrasonication induced nano-emulsification of thyme essential oil: Optimization and antibacterial mechanism against Escherichia coli. Food Control 2022, 133, 108609. [Google Scholar] [CrossRef]
- Kang, J.-H.; Park, S.-J.; Park, J.-B.; Song, K.B. Surfactant type affects the washing effect of cinnamon leaf essential oil emulsion on kale leaves. Food Chem. 2019, 271, 122–128. [Google Scholar] [CrossRef] [PubMed]
- Pongsumpun, P.; Iwamoto, S.; Siripatrawan, U. Response surface methodology for optimization of cinnamon essential oil nanoemulsion with improved stability and antifungal activity. Ultrason. Sonochemistry 2020, 60, 104604. [Google Scholar] [CrossRef]
- Hassanin, M.A.M.; Halawa, A.E.; Ali, A.A.A. Evaluation of the activity of thyme essential oil nanoemulsion against Sclerotinia rot of fennel. Egypt. J. Agric. Res. 2017, 95, 1037–1050. [Google Scholar] [CrossRef]
- Gupta, P.; Preet, S.; Singh, A.; Singh, N. Preparation of Thymus vulgaris (L.) essential oil nanoemulsion and its chitosan encapsulation for controlling mosquito vectors. Sci. Rep. 2022, 12, 4335. [Google Scholar] [CrossRef]
- El-Sayed, S.M.; El-Sayed, H.S. Antimicrobial nanoemulsion formulation based on thyme (Thymus vulgaris) essential oil for UF labneh preservation. J. Mater. Res. Technol. 2021, 10, 1029–1041. [Google Scholar] [CrossRef]
- Sundararajan, B.; Moola, A.K.; Vivek, K.; Kumari, B.R. Formulation of nanoemulsion from leaves essential oil of Ocimum basilicum L. and its antibacterial, antioxidant and larvicidal activities (Culex quinquefasciatus). Microb. Pathog. 2018, 125, 475–485. [Google Scholar] [CrossRef]
- Chouhan, S.; Sharma, K.; Guleria, S. Antimicrobial activity of some essential oils—Present status and future perspectives. Medicines 2017, 4, 58. [Google Scholar] [CrossRef] [PubMed]
- Xu, J.; Zhou, F.; Ji, B.P.; Pei, R.S.; Xu, N. The antibacterial mechanism of carvacrol and thymol against Escherichia coli. Lett. Appl. Microbiol. 2008, 47, 174–179. [Google Scholar] [CrossRef] [PubMed]
- Jamali, T.; Kavoosi, G.; Safavi, M.; Ardestani, S.K. In-vitro evaluation of apoptotic effect of OEO and thymol in 2D and 3D cell cultures and the study of their interaction mode with DNA. Sci. Rep. 2018, 8, 15787. [Google Scholar] [CrossRef] [PubMed]
- Salehi, F.; Behboudi, H.; Salehi, E.; Ardestani, S.K.; Piroozmand, F.; Kavoosi, G. Apple pectin-based Zataria multiflora essential oil (ZEO) nanoemulsion: An approach to enhance ZEO DNA damage induction in breast cancer cells as in vitro and in silico studies reveal. Front. Pharmacol. 2022, 13, 946161. [Google Scholar] [CrossRef]
- Shirisha, A.; Vijayakumar, A. Minimum Inhibitory Concentration (MIC) and Minimum Bacterial Concentration (MBC) Evaluation of Green Synthesised Silver Nanoparticles on Staphylococcus aureus and Streptococcus agalactiae. Int. J. Vet. Sci. Anim. Husb. 2023, 8, 244–249. [Google Scholar] [CrossRef]
- Kowalczyk, A.; Przychodna, M.; Sopata, S.; Bodalska, A.; Fecka, I. Thymol and Thyme Essential Oil-New Insights into Selected Therapeutic Applications. Molecules 2020, 25, 4125. [Google Scholar] [CrossRef]
- Zhang, J.; Ma, S.; Du, S.; Chen, S.; Sun, H. Antifungal activity of thymol and carvacrol against postharvest pathogens Botrytis cinerea. J. Food Sci. Technol. 2019, 56, 2611–2620. [Google Scholar] [CrossRef]
- Moazeni, M.; Davari, A.; Shabanzadeh, S.; Akhtari, J.; Saeedi, M.; Mortyeza-Semnani, K.; Abastabar, M.; Nabili, M.; Moghadam, F.H.; Roohi, B.; et al. In vitro antifungal activity of Thymus vulgaris essential oil nanoemulsion. J. Herb. Med. 2021, 28, 100452. [Google Scholar] [CrossRef]
- Miastkowska, M.; Michalczyk, A.; Figacz, K.; Sikora, E. Nanoformulations as a modern form of biofungicide. J. Environ. Health Sci. Eng. 2020, 18, 119–128. [Google Scholar] [CrossRef]
- Nazzaro, F.; Fratianni, F. Essential Oils and Antifungal Activity. Pharmaceuticals 2017, 10, 86. [Google Scholar] [CrossRef]
- Gallego-Jara, J.; Lozano-Terol, G.; Sola-Martínez, R.A.; Cánovas-Díaz, M.; de Diego Puente, T. A Compressive Review about Taxol®: History and Future Challenges. Molecules 2020, 25, 5986. [Google Scholar] [CrossRef] [PubMed]
- Tawfik, N.M.; Teiama, M.S.; Iskandar, S.S.; Osman, A.; Hammad, S.F. A Novel Nanoemulsion Formula for an Improved Delivery of a Thalidomide Analogue to Triple-Negative Breast Cancer; Synthesis, Formulation, Characterization and Molecular Studies. Int. J. Nanomed. 2023, 18, 1219–1243. [Google Scholar] [CrossRef] [PubMed]
- Abd-Rabou, A.A.; Edris, A.E. Cytotoxic, apoptotic, and genetic evaluations of Nigella sativa essential oil nanoemulsion against human hepatocellular carcinoma cell lines. Cancer Nanotechnol. 2021, 12, 28. [Google Scholar] [CrossRef]
- Gong, L.; Tang, Y.; An, R.; Lin, M.; Chen, L.; Du, J. RTN1-C mediates cerebral ischemia/reperfusion injury via ER stress and mitochondria-associated apoptosis pathways. Cell Death Dis. 2017, 8, e3080. [Google Scholar] [CrossRef] [PubMed]
- Falcon, B.L.; Chintharlapalli, S.; Uhlik, M.T.; Pytowski, B. Antagonist antibodies to vascular endothelial growth factor receptor 2 (VEGFR-2) as anti-angiogenic agents. Pharmacol. Ther. 2016, 164, 204–225. [Google Scholar] [CrossRef]
- Hashem, A.H.; Abdelaziz, A.M.; Hassanin, M.M.H.; Al-Askar, A.A.; AbdElgawad, H.; Attia, M.S. Potential Impacts of Clove Essential Oil Nanoemulsion as Bio Fungicides against Neoscytalidium Blight Disease of Carum carvi L. Agronomy 2023, 13, 1114. [Google Scholar] [CrossRef]
- Saloko, S.; Darmadji, P.; Setiaji, B.; Pranoto, Y.; Anal, A. Encapsulation of coconut shell liquid smoke in chitosan-maltodextrin based nanoparticles. Int. Food Res. J. 2013, 20, 1269. [Google Scholar]
- Xue, J.; Luo, Y.; Li, B.; Wang, X.; Xiao, Z.; Luo, Y. Antimicrobial effects of thymol-loaded phytoglycogen/zein nanocomplexes against foodborne pathogens on fresh produce. Int. J. Biol. Macromol. 2022, 209, 1188–1196. [Google Scholar] [CrossRef]
- Parveen, S. All natural and clean-label preservatives and antimicrobial agents used during poultry processing and packaging. J. Food Prot. 2017, 80, 540–544. [Google Scholar]
- Parvekar, P.; Palaskar, J.; Metgud, S.; Maria, R.; Dutta, S. The minimum inhibitory concentration (MIC) and minimum bactericidal concentration (MBC) of silver nanoparticles against Staphylococcus aureus. Biomater. Investig. Dent. 2020, 7, 105–109. [Google Scholar] [CrossRef]
- Clinical and Laboratory Standards Institute M27-A2. Reference Method for Broth Dilution Antifungal Susceptibility Testing of Yeasts; National Committee for Clinical Laboratory Standards: Wayne, PA, USA, 2002. [Google Scholar]
- Clinical and Laboratory Standards Institute. Performance standards for antimicrobial susceptibility testing. Clin. Lab Stand. Inst. 2016, 35, 16–38. [Google Scholar]
- Cantón, E.; Pemán, J.; Viudes, A.; Quindós, G.; Gobernado, M.; Espinel-Ingroff, A. Minimum fungicidal concentrations of amphotericin B for bloodstream Candida species. Diagn. Microbiol. Infect. Dis. 2003, 45, 203–206. [Google Scholar] [CrossRef] [PubMed]
- Fritsch, M.; Günther, S.D.; Schwarzer, R.; Albert, M.-C.; Schorn, F.; Werthenbach, J.P.; Schiffmann, L.M.; Stair, N.; Stocks, H.; Seeger, J.M.; et al. Caspase-8 is the molecular switch for apoptosis, necroptosis and pyroptosis. Nature 2019, 575, 683–687. [Google Scholar] [CrossRef] [PubMed]
- Abdel-Mohsen, H.T.; Abdullaziz, M.A.; El Kerdawy, A.M.; Ragab, F.A.F.; Flanagan, K.J.; Mahmoud, A.E.E.; Ali, M.M.; El Diwani, H.I.; Senge, M.O. Targeting Receptor Tyrosine Kinase VEGFR-2 in Hepatocellular Cancer: Rational Design, Synthesis and Biological Evaluation of 1,2-Disubstituted Benzimidazoles. Molecules 2020, 25, 770. [Google Scholar] [CrossRef] [PubMed]

| K. oxytoca | E. coli | B. subtilis | S. aureus | |||||
|---|---|---|---|---|---|---|---|---|
| IZ/mm | MIC50 (mg/mL) | IZ/mm | MIC50 (mg/mL) | IZ/mm | MIC50 (mg/mL) | IZ/mm | MIC50 | |
| Thymol emulsion | 14 ± 2.1 | ND | 19 ± 1.8 | ND | 18 ± 1.8 | ND | 16 ± 1.8 | ND |
| Thymol nanoemulsion | 21 ± 1.9 | 62.5 | 23 ± 2.4 | 62.5 | 25 ± 3.9 | 250 | 26 ± 2.8 | 125 |
| Ciprofloxacin | 14 ± 3.2 | 50 | 16 ± 29 | 100 | 22 ± 29 | 50 | 21 ± 29 | 50 |
| Fungal Strain Used | Inhibition Zone/mm | MIC/MFC (mg/mL) | |||
|---|---|---|---|---|---|
| Th-Emulsion | Th-Nanoemulsion | NS | Th-Emulsion | Th-Nanoemulsion | |
| A.brasiliensis | 13.2 ± 1.41 | 20.5 ± 1.32 | 10.2 ± 1.22 | 50/100 | 12.5/50 |
| A. fumigatus | 18.3 ± 1.1 | 26.4 ± 1.34 | 9.6 ± 0.57 | 12.5/50 | 6.25/12.5 |
| C. albicans | 12.7 ± 0.88 | 12.0 ± 0.90 | ND | 50/100 | 50/100 |
Disclaimer/Publisher’s Note: The statements, opinions and data contained in all publications are solely those of the individual author(s) and contributor(s) and not of MDPI and/or the editor(s). MDPI and/or the editor(s) disclaim responsibility for any injury to people or property resulting from any ideas, methods, instructions or products referred to in the content. |
© 2023 by the authors. Licensee MDPI, Basel, Switzerland. This article is an open access article distributed under the terms and conditions of the Creative Commons Attribution (CC BY) license (https://creativecommons.org/licenses/by/4.0/).
Share and Cite
Doghish, A.S.; Shehabeldine, A.M.; El-Mahdy, H.A.; Hassanin, M.M.H.; Al-Askar, A.A.; Marey, S.A.; AbdElgawad, H.; Hashem, A.H. Thymus Vulgaris Oil Nanoemulsion: Synthesis, Characterization, Antimicrobial and Anticancer Activities. Molecules 2023, 28, 6910. https://doi.org/10.3390/molecules28196910
Doghish AS, Shehabeldine AM, El-Mahdy HA, Hassanin MMH, Al-Askar AA, Marey SA, AbdElgawad H, Hashem AH. Thymus Vulgaris Oil Nanoemulsion: Synthesis, Characterization, Antimicrobial and Anticancer Activities. Molecules. 2023; 28(19):6910. https://doi.org/10.3390/molecules28196910
Chicago/Turabian StyleDoghish, Ahmed S., Amr M. Shehabeldine, Hesham A. El-Mahdy, Mahmoud M. H. Hassanin, Abdulaziz A. Al-Askar, Samy A. Marey, Hamada AbdElgawad, and Amr H. Hashem. 2023. "Thymus Vulgaris Oil Nanoemulsion: Synthesis, Characterization, Antimicrobial and Anticancer Activities" Molecules 28, no. 19: 6910. https://doi.org/10.3390/molecules28196910
APA StyleDoghish, A. S., Shehabeldine, A. M., El-Mahdy, H. A., Hassanin, M. M. H., Al-Askar, A. A., Marey, S. A., AbdElgawad, H., & Hashem, A. H. (2023). Thymus Vulgaris Oil Nanoemulsion: Synthesis, Characterization, Antimicrobial and Anticancer Activities. Molecules, 28(19), 6910. https://doi.org/10.3390/molecules28196910

